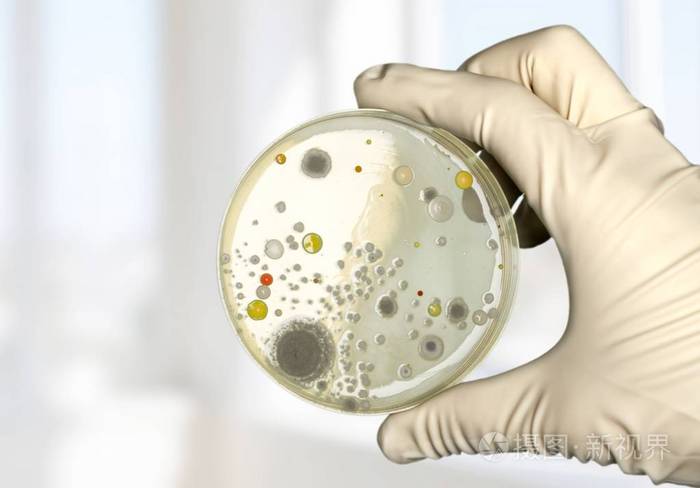
在科学家手中微生物学实验室测试

微生物实验

微生物实验室中科学家实验室技术员接种环培养板细菌接种研究
图片尺寸700x467
实验员观察微生物菌落
图片尺寸1200x800
在科学家手中微生物学实验室测试
图片尺寸700x467
在科学家手中微生物学实验室测试
图片尺寸700x488
戴森微生物实验室
图片尺寸2048x1365
微生物实验室的安全管理和环境要求包括哪些?
图片尺寸1280x720
庆阳市第二人民医院临床微生物实验室成立了
图片尺寸640x429
微生物实验室常见错误操作你中了几条
图片尺寸1080x485
环境微生物实验(中国海洋大学环境科学与工程国家级实验教学示范中心
图片尺寸800x800
微生物实验室
图片尺寸1920x1080
默克微生物监测实验室邀您参观
图片尺寸764x510
浅谈职业技术教育微生物实验课的改革
图片尺寸858x607
食品微生物检测实训第四期报道帖
图片尺寸668x622
家手中微生物学实验室测试显微镜下的微生物微生物实验室中科学家实验
图片尺寸450x300
微生物在实验室培养基培养板上扩散.
图片尺寸1200x800
加拿大微生物实验室发现感染新冠症状8天后,不再具有传染性?
图片尺寸718x475
食品微生物实验室操作过程需要注意什么如何保证无菌操作
图片尺寸517x381
美素精选图库 在科学家手中微生物学实验室测试
图片尺寸600x400
正式启用丨863化妆品功效评价中心及微生物实验室
图片尺寸4032x3024
食品微生物实验室操作过程的注意事项
图片尺寸372x298